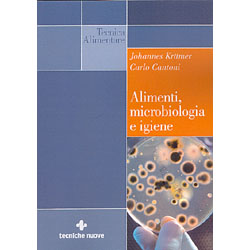

|
| LIBRI | MUSICA E VIDEO | CARTOLERIA | REGALO E BENESSERE |
| EDIZIONI LIBRAIO DELLE STELLE | EDIZIONI FIORI GIALLI |
|
 |
| EDIZIONI LIBRAIO DELLE STELLE | EDIZIONI FIORI GIALLI |
| www.illibraiodellestelle.com - www.illibraiodellestelle.it |
Il Libraio delle Stelle - via Colle dell'Acero 20 - 00049 Velletri - P.Iva 00204351001
| made by 3ml.it |